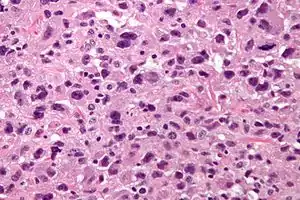

Undifferentiated pleomorphic sarcoma
Undifferentiated pleomorphic sarcoma, previously malignant fibrous histiocytoma, is a type of cancer, namely a soft-tissue sarcoma.
| Undifferentiated pleomorphic sarcoma | |
|---|---|
| Other names | UPS |
![]() | |
| Micrograph of undifferentiated pleomorphic sarcoma (H&E stain) | |
| Specialty | Oncology |
It is considered a diagnosis of exclusion for sarcomas that cannot be more precisely categorized.[1][2] Other sarcomas are cancers that form in bone and soft tissues, including muscle, fat, blood vessels, lymph vessels, and fibrous tissue (such as tendons and ligaments).[3]
Presentation
UPS occurs most commonly in the extremities and retroperitoneum, but has been reported in other sites. Metastasis occurs most frequently in the lungs (90%), bones (8%), and liver (1%).
In the extremities, it presents itself as a painless, enlarging, soft-tissue mass.
Diagnosis
It can be detected by magnetic resonance imaging (MRI), but a biopsy is required for the definitive diagnosis. MRI findings typically show a well-circumscribed mass that is dark on T1-weighted images and bright on T2-weighted images. Central necrosis is often present and identifiable by imaging, especially in larger masses.
Pathology
UPSs are, by definition, undifferentiated, meaning (as the name implies) that they do not bear a resemblance to any normal tissue.
The histomorphology, otherwise, is characterized by high cellularity, marked nuclear pleomorphism, usually accompanied by abundant mitotic activity (including atypical mitoses), and a spindle cell morphology. Necrosis is common and characteristic of high-grade lesions.
Treatment
Treatment consists of surgical excision (the extent of which ranges from tumor excision to limb amputation, depending on the tumor) and in almost all cases radiation. Radiation eliminates the need for limb amputation and there is level I evidence to show that it leads to equivalent rates of survival (Rosenberg et al. NCI). Radiation may be delivered either pre-op or post-op depending on surgeon and multidisciplinary tumor board's recommendations. Radiation can be omitted for low grade, Stage I excised tumors with >1 cm margin (NCCN). Chemotherapy remains controversial in MFH.
The usual site of metastatic disease is the lungs, and metastases should be resected if possible. Unresectable or inoperable lung metastasis may be treated with stereotactic body radiation therapy (SBRT) with excellent local control. However, neither surgery nor SBRT will prevent emergence of additional metastases elsewhere in the lung. Therefore, the role of chemotherapy needs to be further explored to address systemic metastasis.
Prognosis
Prognosis depends on the primary tumor grade (appearance under the microscope as judged by a pathologist), size, resectability (whether it can be completely removed surgically), and presence of metastases. The five-year survival rate is 80%. High expression levels of AMPD2 have been shown to correlate with poor patient outcome and a proliferative tumor phenotype in UPS.[4]
Epidemiology
UPS is regarded as the most common soft-tissue sarcoma of late adult life. It rarely occurs in children.[5] It occurs more often in Caucasians than in those of African or Asian descent and is a male-predominant disease, afflicting two males for every female.
Transmission
An undifferentiated pleomorphic sarcoma was transplanted from a patient to a surgeon when he injured his hand during an operation.[6]
References
- Matushansky I, Charytonowicz E, Mills J, Siddiqi S, Hricik T, Cordon-Cardo C (August 2009). "MFH classification: differentiating undifferentiated pleomorphic sarcoma in the 21st Century". Expert Review of Anticancer Therapy. 9 (8): 1135–44. doi:10.1586/era.09.76. PMC 3000413. PMID 19671033.
- "Neoplasia".
- "What Is Cancer?". National Cancer Institute. 2007-09-17. Retrieved 2017-11-26.
- Orth MF, Gerke JS, Knösel T, Altendorf-Hofmann A, Musa J, Alba-Rubio R, et al. (February 2019). "Functional genomics identifies AMPD2 as a new prognostic marker for undifferentiated pleomorphic sarcoma". International Journal of Cancer. 144 (4): 859–867. doi:10.1002/ijc.31903. PMID 30267407.
- Alaggio R, Collini P, Randall RL, Barnette P, Million L, Coffin CM (2010). "Undifferentiated high-grade pleomorphic sarcomas in children: a clinicopathologic study of 10 cases and review of literature". Pediatric and Developmental Pathology. 13 (3): 209–17. doi:10.2350/09-07-0673-OA.1. PMID 20055602. S2CID 207375791.
- Gärtner HV, Seidl C, Luckenbach C, Schumm G, Seifried E, Ritter H, Bültmann B (November 1996). "Genetic analysis of a sarcoma accidentally transplanted from a patient to a surgeon". The New England Journal of Medicine. 335 (20): 1494–6. doi:10.1056/NEJM199611143352004. PMID 8890100.
External links
| Classification | |
|---|---|
| External resources |